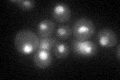
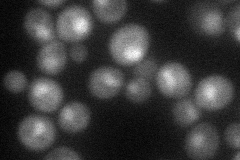
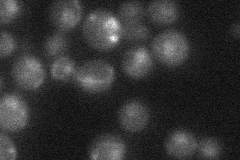

View description
Putative endoribonuclease, subunit of the mRNA cleavage and polyadenylation specificity complex; required for 3' processing, splicing, and transcriptional termination of mRNAs and snoRNAs
Localization:
Intensity:
Fold change:
Significance:
-
C’ GFP library in SD
nucleus29.46 -
N' NOP1pr-GFP in SD

nucleolus54.9506 -
N' TEF2pr-mCherry in SD
nucleus31.7044 -
N' NATIVEpr-GFP in SD
nucleus24.9491 -
N' TEF2pr-VC and Cyto-VN in SD

#N/A0 -
C’ GFP library in SD+DTT

nucleus26.760.9No -
C’ GFP library in SD+H2O2

nucleus27.190.92No -
C’ GFP library in Starvation Media

nucleus25.070.85No -
C’ GFP library on the background of Pup2-DaMP

nucleus -
C’ GFP library on the background of CCT mutant

nucleus29.70761.00812No
